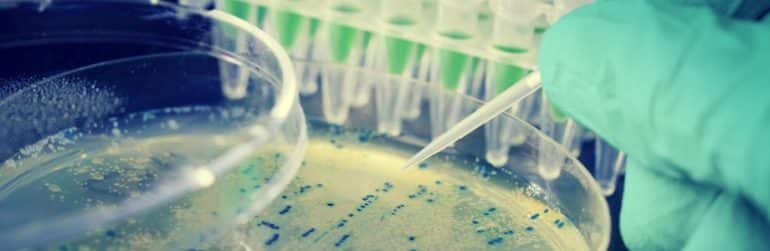
probiotique-bacterie-assaut-obesite

La recherche sur les probiotiques et les prébiotiques suggère un ensemble d’effets potentiels bénéfiques pour la digestion du nourrisson. Cependant, les effets décrits ne peuvent être attribués qu’aux souches testées. Le moment d’administration aurait aussi son importance.
La recommandation concernant les prébiotiques et/ou les probiotiques chez les nourrissons progresse en pratique clinique, que ce soit via les préparations ou certaines formules prophylactiques comme les gouttes. Cette approche est prometteuse, elle a pour l’instant déjà démontré son intérêt dans certains cas, en particulier dans la bonne santé intestinale du nouveau-né.
Prébiotique n’est pas probiotique
Pré- et probiotiques sont souvent confondus, alors que les deux concepts cachent en réalité, rappelons-le, deux approches bien différentes. Les prebiotiques augmentent le nombre de bactéries anaérobies considérées comme bénéfiques et diminuent la population des microorganismes potentiellement pathogènes. Les probiotiques, quant à eux, influencent l’écosystème intestinal ou microbiote, en stimulant les mécanismes immunitaires muqueux et les mécanismes non immunitaires par antagonisme et par compétition avec les pathogènes potentiels.
Les deux phénomènes induisent vraisemblablement la plupart des effets positifs observés à ce jour, incluant la réduction de l’incidence et de la sévérité des diarrhées, qui constitue leur principale indication clinique. Et rien n’est plus vrai dans leur utilisation en pédiatrie.
Un consensus sur la diarrhée aiguë pour certaines souches
Chez le nourrisson, en 2011, un position paper de l’European Society of Paediatric Gastroenterology, Hepatology and Nutrition et des guidelines de la World Gastroenterology Organization ont passé au crible la littérature scientifique portant sur l’administration de pré- et probiotiques chez le nourrisson. Les deux revues aboutissent globalement aux trois mêmes conclusions.
Premièrement, leur innocuité pour la santé du nourrisson est bien établie et leur emploi n’affecterait pas la croissance. Deuxièmement, les probiotiques ont fait l’objet d’un plus grand nombre d’études que les prébiotiques. Troisièmement, l’efficacité des probiotiques dépend strictement des souches et n’est donc pas généralisable.
Les deux instances reconnaissent à ce sujet que les souches L. reuteri ATCC 55730, L. rhamnosus GG, L. casei DN-114 001 et Saccharomyces cerevisiae (boulardii) ont prouvé leur utilité dans la réduction de la sévérité et de la durée des diarrhées infectieuses aiguës chez l’enfant. L’administration orale de probiotiques réduit significativement la durée de la maladie diarrhéique aigüe chez l’enfant d’environ un jour. Les résultats sont également plus convaincants pour les infections d’origine virale.
Une revue belge récente de la littérature a confirmé ces évidences et ajoute aussi dans la diarrhée associée aux antibiotiques, une forte évidence d’efficacité en prévention pour S. boulardii ou L. rhamnosus GG chez l’enfant sous traitement antibiotique. Dans une étude clinique contrôlée, L. reuteri ATC 55730 s’est par ailleurs avéré efficace pour réduire de manière significative le risque de diarrhée associée aux antibiotiques chez l’enfant et chez les adultes hospitalisés.
Moins de coliques, moins de pleurs, plus d’économies?
L’avantage observé aujourd’hui des probiotiques sur les prébiotiques se mesure aussi en prévention chez les nourrissons en bonne santé, ce qui montre l’importance du momentum. Récemment, une étude publiée dans le JAMA Pediatrics rapporte que la supplémentation avec un probiotique, le Lactobacillus reuteri DSM17938 distribué en gouttes (1x 108 CFU) pouvait contribuer à réduire l’apparition de troubles gastro-intestinaux fonctionnels, tels que les coliques du nourrisson.
Cette étude multicentrique italienne, randomisée et contrôlée en double aveugle, a impliqué 589 nouveau-nés suivis pendant leurs trois premiers mois de vie. Les résultats révèlent, dès le premier mois, une réduction de 53% des épisodes de pleurs dans le groupe d’intervention, en comparaison du placebo (45 minutes versus 96 minutes).
Au terme de l’étude, les enfants recevant le probiotique ont également montré une meilleure motilité intestinale, avec 30% d’exonérations supplémentaires au quotidien, ainsi que moins de régurgitations (-37% vs contrôles). Enfin, les auteurs de l’étude ont évalué le rapport coûts/bénéfices de l’intervention, en calculant uniquement les coûts directs: il se solde par une économie de 88e par enfant par famille et de 104e par enfant pour la communauté.
Quand le nourrisson baisse naturellement ses défenses…
La complexité de la compréhension du rôle et la définition de la fenêtre d’action idéale des probiotiques et des prébiotiques chez le nourrisson pourrait aussi tenir au décryptage d’un phénomène relaté par des pédiatres américains dans une édition récente du magazine Nature.
Selon ces chercheurs, la vulnérabilité des nourrissons aux infections bactériennes ne serait pas nécessairement un signe d’immaturité ou même une mauvaise chose: au contraire, cela pourrait s’avérer positif pour lui! Dans leurs expérimentations menées chez le rongeur, ils ont découvert que les jeunes ratons désactivaient «délibérément» leur système immunitaire pour une période de temps critique.
Sur un plan physiologique, cette période consisterait à faciliter la colonisation bactérienne du tube digestif et une plus grande diversité du microbiote. Pour les auteurs, cette période «permissive» pourrait être essentielle à la santé future du nouveau-né. Ils ont également identifié une protéine chef d’orchestre de ce phénomène au sein des globules rouges: la CD7, qui aurait pratiquement disparu dans le sang des souris adultes et supprimerait l’expression du système immunitaire, notamment en activant une enzyme appelée arginase.
Si ces recherches sont confirmées chez l’homme, elles pourraient rapidement conduire à des applications pratiques, comme un traitement plus efficace des infections du nourrisson ou, pourquoi pas, des interventions nutritionnelles mieux ciblées à partir de probiotiques ou de prébiotiques…
FIA 22_Mars 2014
Références: Global Guideline Probiotics and prebiotics, WGO, 2011. ESPGHAN Commitee on Nutrition, JPGN, 2011; 52: 238-250. Vandenplas Y. et al., Curr Infect Dis Rep, 2013 Jun, 15(3): 251-62. Lionetti E. et al., Aliment Pharmacol Ther, 2006, 24, 1461-1468. Cimperman L. et al., J Clin Gastroenterol, 2011 Oct, 45 (9): 785-9. Indrio F. et al., JAMA Pediatrics, 13/01/2014. Shokrollah E. et al., Nature, 6/11/2013.